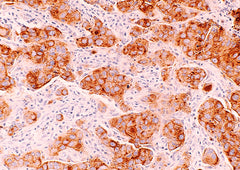

Publications

2024
Dynamic changes in tumor profiling reveal intra- and intertumoral heterogeneity focused on an uncharacterized HER2 mutation: a case report of a young breast cancer patient

2024
Liquid Biopsy for Detection of Pancreaticobiliary Cancers by Functional Enrichment and Immunofluorescent Profiling of Circulating Tumor Cells and Their Clusters

2023
Profiling of circulating glial cells for accurate blood-based diagnosis of glial malignancies
2022
Accurate Screening for Early-Stage Breast Cancer by Detection and Profiling of Circulating Tumor Cells

2022
Case Report: Extensive Tumor Profiling in Primary Neuroendocrine Breast Cancer Cases as a Role Model for Personalized Treatment in Rare and Aggressive Cancer Types

2021
Excellent Response With Alpelisib and Bicalutamide for Advanced Salivary Duct Carcinoma With PIK3CA Mutation and High Androgen Receptor Expression-A Case Report

2021
Development and validation of a multigene variant profiling assay to guide targeted and immuno therapy selection in solid tumors

2021
Improved Treatment Outcomes by Using Patient Specific Drug Combinations in Mammalian Target of Rapamycin Activated Advanced Metastatic Cancers

2021
Angiogenesis Inhibitors in Personalized Combination Regimens for the Treatment of Advanced Refractory Cancers

2020
Hallmark Circulating Tumor-Associated Cell Clusters Signify 230 Times Higher One-Year Cancer Risk

2020
Evaluation of Circulating Tumor Cell Clusters for Pan-Cancer Noninvasive Diagnostic Triaging

2020
A case report of androgen receptor inhibitor therapy in recurrent high-grade serous ovarian cancer

2020
Clinical utility of circulating tumor‑associated cells to predict and monitor chemo‑response in solid tumors

2020
Long Overall Survival in a Case of Refractory Stage IV Squamous Cell Carcinoma of Lung Treated with Personalized De Novo Combination Regimen

2019
Circulating ensembles of tumor-associated cells: A redoubtable new systemic hallmark of cancer

2019
Encyclopedic tumor analysis for guiding treatment of advanced, broadly refractory cancers: results from the RESILIENT trial

2019
Adaptive, Iterative, Long-Term Personalized Therapy Management in a Case of Stage IV Refractory NSCLC